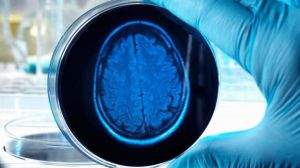
artificialbrain3

हमारे बड़े बुज़ुर्ग हमेशा ये बात कहते हैं कि मानव चाहे जितनी प्रगति कर ले लेकिन वो ईश्वर नहीं बन सकता। यानि जो चीज़ें प्रकृति ने अपने हाथ में रखी हैं उनमें किसी तरह का परिवर्तन नहीं किया जा सकता। ना ही वैसी चीज़ें वो पैदा कर सकता है। इसमें सबसे महत्वपूर्ण है मानव का जन्म। यानि दुनिया में ऐसी कोई ताक़त नहीं जो मानव को पैदा कर सके या मानव शरीर के किसी भी हिस्से को वो अलग से बना सके।
हमारे बड़े बुज़ुर्ग हमेशा ये बात कहते हैं कि मानव चाहे जितनी प्रगति कर ले लेकिन वो ईश्वर नहीं बन सकता। यानि जो चीज़ें प्रकृति ने अपने हाथ में रखी हैं उनमें किसी तरह का परिवर्तन नहीं किया जा सकता। ना ही वैसी चीज़ें वो पैदा कर सकता है। इसमें सबसे महत्वपूर्ण है मानव का जन्म। यानि दुनिया में ऐसी कोई ताक़त नहीं जो मानव को पैदा कर सके या मानव शरीर के किसी भी हिस्से को वो अलग से बना सके।
हालांकि आज विज्ञान ने इतनी तरक़्क़ी कर ली है कि वो टेस्ट ट्यूब बेबी पैदा कर सकता है। क्लोन की मदद से एक ही मानव जैसे कई मानव भी बना सकता है। आज तो प्रयोगशाला में ही मानव के शरीर के अंग बनाए जा रहे हैं।
ऐसा ही एक प्रयोग किया जा रहा है कैंब्रिज यूनिवर्सिटी की मोलिक्यूलर बायोलोजी प्रयोगशाला में। जहां मानव की चमड़ी से मानव का मस्तिष्क बनाने की कोशिश की जा रही है। यहां मस्तिष्क का विकास उसी तरह से किया जा रहा है जैसे मां के पेट में एक बच्चे का होता है।
अंतर केवल इतना है कि मां के पेट में मस्तिष्क का विकास खून की आपूर्ती से होता है। मां जो पोषक तत्व लेती है वही बच्चे को मिलते हैं। वहीं, इस प्रयोगशाला में जिस मस्तिष्क को बनाया जा रहा है, उसे ज़रूरी चीज़ें दूसरी शक़्ल में मुहैया कराई जा रही हैं। इस बात का विशेष ध्यान जा रहा है कि परखनली में उपज रहे मस्तिष्क को इन्फेक्शन न हो जाए। इसीलिए जिस माहौल में विकसित होते नन्हे मस्तिष्क रखे जाते हैं, उस पर ख़ास निगरानी होती है। जिस चीज़ में इन नन्हे मस्तिष्कों को रखा जाता है, पहले उसे अल्कोहल से साफ़ किया जाता है, ताकि कोई इन्फेक्शन न हो।
 अगर आप प्रयोगशाला में तैयार किए जा रहे मस्तिष्क को देखेंगें तो हो सकता है ये आपको उतने आकर्षक ना लगें। क्योंकि अभी वो पूरी तरह से विकसित नहीं हुए हैं। आप देखेंगे कि हल्के पीले और गुलाबी रंग के लिक्विड में पानी के बुलबुले जैसे कोई चीज़ तैर रही है। लेकिन ये बिल्कुल ऐसे ही विकसित हो रहा है जैसे किसी भी मानव का मस्तिष्क मां के गर्भ में विकसित होता है।
अगर आप प्रयोगशाला में तैयार किए जा रहे मस्तिष्क को देखेंगें तो हो सकता है ये आपको उतने आकर्षक ना लगें। क्योंकि अभी वो पूरी तरह से विकसित नहीं हुए हैं। आप देखेंगे कि हल्के पीले और गुलाबी रंग के लिक्विड में पानी के बुलबुले जैसे कोई चीज़ तैर रही है। लेकिन ये बिल्कुल ऐसे ही विकसित हो रहा है जैसे किसी भी मानव का मस्तिष्क मां के गर्भ में विकसित होता है।
जिस तरह मानव के मस्तिष्क के अलग अलग हिस्से होते हैं, उसी तरह प्रयोगशाला में विकसित हो रहे इस मस्तिष्क के भी कई हिस्से हैं। जैसे इसमें जो सुरमई हिस्सा है वो न्यूरॉन्स से बना है। और जहां आपको थोड़े मोटे टिशू नज़र आंगे वहां उसकी एक छोटी सी दुम विकसित हो रही है। इसका सीधा ताल्लुक़ रीढ़ की हड्डी से है। दरअसल मानव के मस्तिष्क में ये वो हिस्सा होता है जहां भाषा को समझने की विशेषता होती है। और सोचने की प्रक्रिया मस्तिष्क के इसी हिस्से में होती है।
दूसरा हिस्सा है हिप्पोकैंपस। ये मस्तिष्क का वो हिस्सा है जो स्मृति और भावनाओं को नियंत्रण करता है। ये सभी हिस्से प्रयोगशाला में विकसित हो रहे इस मस्तिष्क में भी हैं। पूरी तरह से तैयार होने पर ये बिल्कुल ऐसे ही लगेगा जैसे एक नौ महीने के बच्चे का मस्तिष्क लगता है।
मानव मस्तिष्कों की ये खेती कैसे की जा रही है?
प्रश्न ये है कि आख़िर मानव मस्तिष्कों की ये खेती कैसे की जा रही है? विशेषज्ञो का कहना है कि प्रयोगशाला में मस्तिष्क बनाना कोई इतना कठिन कार्य नहीं, जितना देखने, सुनने में लगता है।
सबसे पहले उसके लिए कुछ कोशिकाओं की आवश्यकता है। कैंब्रिज यूनिवर्सिटी में इन मस्तिष्कों को तैयार करने वाली टीम की प्रमुख हैं मैडेलीन लैंकेस्टर।
लैंकेस्टर का कहना है इस काम के लिए नाक, जिगर, पैर के नाखून की कोशिकाएं ली जा सकती हैं। हालांकि उनमें से स्टेम कोशिकाओं को अलग करना होगा। क्योंकि इन्हीं से मानव के बदन के बाक़ी अंग विकसित किए जा सकते हैं।
लैंकेस्टर का कहना है इस काम के लिए नाक, जिगर, पैर के नाखून की कोशिकाएं ली जा सकती हैं। हालांकि उनमें से स्टेम कोशिकाओं को अलग करना होगा। क्योंकि इन्हीं से मानव के बदन के बाक़ी अंग विकसित किए जा सकते हैं।
आप प्रयोगशाला में परखनली में पल रहे मस्तिष्कों को देखेंगे तो आपको एक कोमा के साइज़ का सफ़ेद डॉट नज़र आएगा।
ये बिल्कुल ऐसा ही है जैसा एक भ्रूण का मस्तिष्क होता है। आपने जिस स्टेम कोशिकाओं का इस्तेमाल मस्तिष्क विकसित करने में किया है। वो कुछ दिनों तक पोषक तत्व दिए जाने पर छोटी गेंदों जैसे दिखने लगते हैं। इन्हीं के बीच मस्तिष्क कोशिका या वो कोशिकाएं होती हैं जो आगे चलकर मस्तिष्क के तौर पर विकसित होंगी।
अगला पड़ाव होगा कि बाक़ी कोशिकाओं को ख़त्म करके, सिर्फ़ मस्तिष्क बनाने वाली कोशिकाओं को बचाया जाए। इसके लिए वैज्ञानिक इस गेंद जैसी चीज़ को खाना-पीना देना बंद कर देते हैं। इससे ज़्यादातर कोशिकाएं मर जाती हैं। मगर जिन कोशिकाओं से मस्तिष्क बनना होता है, उनमें संकट झेलने की शक्ति अधिक होती है। इसलिए वो बच जाती हैं। फिर इन्हें अलग करके दूसरी डिश में रखा जाता है।
 प्रोफेसर मैडलीन लैंकेस्टर कहती हैं इन शिशु मस्तिष्क को विकसित करने वाली टीम एक फ़िक्रमंद माता पिता की तरह ही इनकी देखभाल करती है। जब एक ख़ास स्तर तक ये ब्रेन कोशिकाओं विकसित हो जाते हैं तो उन्हें एक जेली जैसे द्रव में डाल दिया जाता है। जो इस शिशु मस्तिष्क के चारों तरफ़ सुरक्षा घेरा बना लेती है। इसके बाद इस मस्तिष्क को ज़रूरी पोषक चीज़ें दी जाती हैं। क़रीब तीन महीने में ये शिशु मस्तिष्क तैयार हो जाते हैं। तीन महीनों में ये मस्तिष्क करीब चार मिलीमीटर को हो जाता है और इसमें क़रीब बीस लाख तंत्रिकाएं होती हैं। आम तौर पर एक चूहे के मस्तिष्क में इतने ही न्यूरॉन होते हैं।
प्रोफेसर मैडलीन लैंकेस्टर कहती हैं इन शिशु मस्तिष्क को विकसित करने वाली टीम एक फ़िक्रमंद माता पिता की तरह ही इनकी देखभाल करती है। जब एक ख़ास स्तर तक ये ब्रेन कोशिकाओं विकसित हो जाते हैं तो उन्हें एक जेली जैसे द्रव में डाल दिया जाता है। जो इस शिशु मस्तिष्क के चारों तरफ़ सुरक्षा घेरा बना लेती है। इसके बाद इस मस्तिष्क को ज़रूरी पोषक चीज़ें दी जाती हैं। क़रीब तीन महीने में ये शिशु मस्तिष्क तैयार हो जाते हैं। तीन महीनों में ये मस्तिष्क करीब चार मिलीमीटर को हो जाता है और इसमें क़रीब बीस लाख तंत्रिकाएं होती हैं। आम तौर पर एक चूहे के मस्तिष्क में इतने ही न्यूरॉन होते हैं।
लैंकेस्टर अपने काम को बहुत बड़ी सफ़लता नहीं मानती हैं।
वो कहती हैं कि ऐसे शिशु मस्तिष्क से हम आम मानव के मस्तिष्क जैसा काम नहीं ले सकते। क्योंकि ये सोचने की क्षमता नहीं रखता है। हालांकि इससे हमें ये समझने में मदद मिलती है कि हमारा मस्तिष्क काम कैसे करता है।
प्रोफ़ेसर मैडलीन लैंकेस्टर कहती हैं प्रयोगशाला में एक पूरी तरह विकसित मस्तिष्क बनाना उनका मक़सद नहीं है। बल्कि इस खोज के ज़रिए वो मानव और बाक़ी जानवरों के मस्तिष्क के काम की तुलना करना चाहती हैं। असल में एक चिंपैंज़ी और मानव के मस्तिष्क में जो जेनेटिक फ़र्क़ है वो बेहद कम है। फिर भी चिंपैंज़ी और मानव के विकास में एक बहुत बड़ा फ़ासला हो गया है।
 इसे समझने के लिए मैडलीन और उनकी टीम ने मानव और चिंपैंज़ी के जीन से नया मस्तिष्क विकसित किया। इस अनुभव में पाया गया कि चिंपैंज़ी के जीन वाले हिस्से में जो तंत्रिकाएं विकसित हुईं वो मानव जीन से बनी कोशिकाओं के मुक़ाबले काफ़ी कमज़ोर थीं।
इसे समझने के लिए मैडलीन और उनकी टीम ने मानव और चिंपैंज़ी के जीन से नया मस्तिष्क विकसित किया। इस अनुभव में पाया गया कि चिंपैंज़ी के जीन वाले हिस्से में जो तंत्रिकाएं विकसित हुईं वो मानव जीन से बनी कोशिकाओं के मुक़ाबले काफ़ी कमज़ोर थीं।
वैसे, प्रयोगशाला में बनाए जा रहे इस कृत्रिम मस्तिष्क से हमें ऑटिज़्म और शिज़ोफ्रेनिया जैसी बीमारियों से निपटने में मदद मिल सकती है। पिछले साल ही वैज्ञानिक ये पता लगाने में कामयाब रहे कि ऑटिज़्म की असल वजह मस्तिष्क में दो तरह के न्यूरोन में ठीक तालमेल नहीं होना है। इस रिसर्च के बाद ही वैज्ञानिक ये भी जान पाए कि जब भ्रूण का मस्तिष्क विकसित हो रहा हो तभी ये बीमारी पकड़ी जा सकती है।
 लैंकेस्टर कहती हैं प्रयोगशाला में मस्तिष्क विकसित करने के बाद मानव के मस्तिष्क को समझने की वैज्ञानिकों की समझ बढ़ी है। और इस दिशा में तेज़ी से काम आगे बढ़ रहा है।
लैंकेस्टर कहती हैं प्रयोगशाला में मस्तिष्क विकसित करने के बाद मानव के मस्तिष्क को समझने की वैज्ञानिकों की समझ बढ़ी है। और इस दिशा में तेज़ी से काम आगे बढ़ रहा है।
वैज्ञानिकों का मक़सद अब प्रयोगशाला में बड़े आकार का मस्तिष्क विकसित करना है। जिससे इन मस्तिष्कों को प्रयोगशाला में उसी तरह काट-पीटकर समझा जा सके, जैसे वैज्ञानिक चूहों के मस्तिष्क के साथ करते हैं।
स्रोत : बी बी सी फ्युचर
http://www.bbc.com/future/story/20161004-were-developing-brains-outside-of-the-body


sir ek रोबोट आज आर्टिफीसियल इंटेलिजेंस kese bna sakte h aur isme kitna kharcha hoga
पसंद करेंपसंद करें
इस लेख मे आपके प्रश्न का उत्तर है।
पसंद करेंपसंद करें
Reblogged this on oshriradhekrishnabole.
पसंद करेंपसंद करें
sir mere ghar pe light nai h i am a poor student
mai ghar me hi 4-6 volt ki bijli bana kar LED bulb jalana chahta hu plz help me sir
पसंद करेंLiked by 1 व्यक्ति
वैभव, आपके लिए सोलर पैनल वाली led ही सर्वोत्तम उपाय है लेकिन शुरुवात में आपको 2000 रूपये खर्च करने होंगे। ये आपको बाजार में मिल जायेगी।
पसंद करेंपसंद करें
thank u sir
apko bahut bahut subh kamnae meri apse ek vinti h plz ap mujhe batry bnane ke bare me kuch btane ki kripa kren
sir maine suna h ki seb se bulb jal jata hai aloo se b electricity paida hoti h kya ye satya h
पसंद करेंपसंद करें
आलु या सेव से बल्ब अल्प समय के लिये कम वोल्टेज वाला बल्ब जल सकता है। लेकिन यह प्रायोगिक नही है।
पसंद करेंपसंद करें
मानव मस्तिष्क भी निर्जीव है किंतु बना हुआ जीवित कोशिकाओं से है। इसलिए मस्तिष्क की जगह काम ले सकते हैं किंतु जो ये सोच रहे हैं कि इंसान इंसान का निर्माण कर सकता है तो ये गलत है क्योंकि वो भी क्लोन या दूसरे बॉडी पार्ट जीवित कोशिका की मदद से बना रहे हैं। हाँ बात तो तब थी जब वो जड़ तत्व से इंसान का निर्माण कर दे।
पसंद करेंपसंद करें
वो समय भी शीघ्र ही आयेगा।
पसंद करेंLiked by 1 व्यक्ति
@सुज्ञान आपकी बात सही है पर इन्सान का इतिहास ज्यादा पुराना भी तो नहीं है … और उनमे से आधी खोज और सिद्धांत हमने खो दिए … २०वीं शतब्दी के बीच तक मोबाइल फ़ोन और कंप्यूटर के बारे में कोई नहीं सोच सकता था … पर ये टेक्नोलॉजी अब हर घर में मोजूद है .. जब तक राईट ब्रदर्स से उड़न नही भरी थी दुनिया के लिए हवा में उड़ना एक सपने जैसा था … लेकिन अब इसे हम नॉर्मली लेते है … जब निकोला टेस्ला ने मोबाइल फ़ोन की प्रेडिक्शन की थी तो सभी को लगा की ये पागल है …मैं ये कह रहा की हम प्रकृति को जीत लेंगे … हमे ऐसा करना भी नही है .. पर इन्सान को सब करने में थोडा वक्त लगेगा …
विज्ञानं और तकनीकी विकास में पीछे रहने के बहुत से कारण … दुनिया के १ प्रतीशत लोगो का भी सीधे तौर विज्ञानं में योगदान नही है …. हमारी रफ़्तार बहुत धीमी है .. आने वाली जनरेशन .. विज्ञानं और दुसरे प्रोडक्टिव कामो में कम रूचि ले रही है … सभी का आकर्षण दूसरी चीजों में है .. वहीँ गरीबी एक बहुत बड़ा फैक्टर है जिसकी वजह से लोग रोटी नही खा पा रहे है विज्ञानं की बात तो छोड़ ही दीजिये ….
इसके बाबजूद हम काफी कुछ कर पाने में सफल ही है … asimo रोबोट आज आर्टिफीसियल इंटेलिजेंस की बेहतर मिसाल है …
थोडा वक्त दीजिये सुज्ञान जी … इन्सान थोडा धीमा ज़रूर है पर कर लेगा …
पसंद करेंपसंद करें